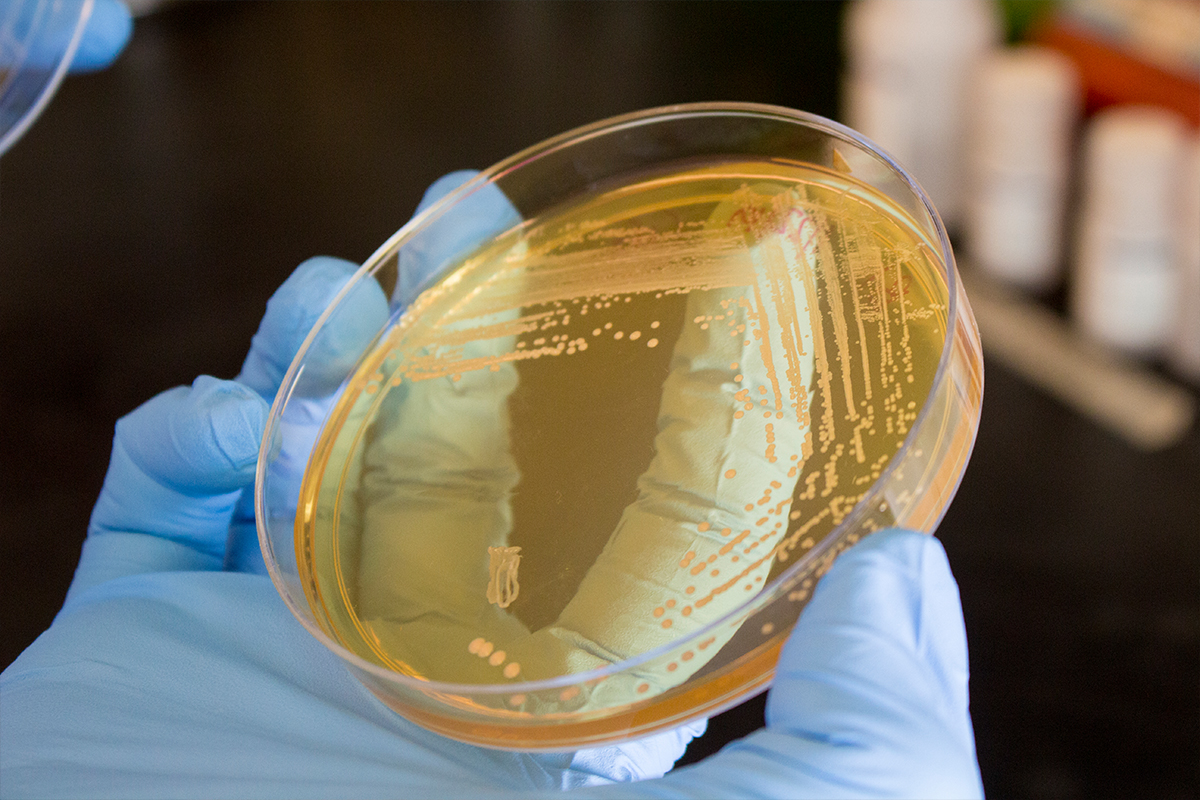
Petri dish

Animal Genetics
Animal genetics studies how and what traits are inherited. Our program focuses on domesticated animals, such as livestock species and pets.
Teaching
Anyone interested in animal genomics can pursue an animal science major within our department.
Research
Our animal genetics research focuses on:
- Genome sequence analysis and functional annotation.
- Genomic changes and animal production.
- The development of models and algorithms to better classify functional interactions.
- The microbiomes of the canine and equine reproductive tracts.
- The role of microbiomes in animal production and health.
Extension
OSU strives to keep the industry and consumers informed with up-to-date research data and outreach efforts.
